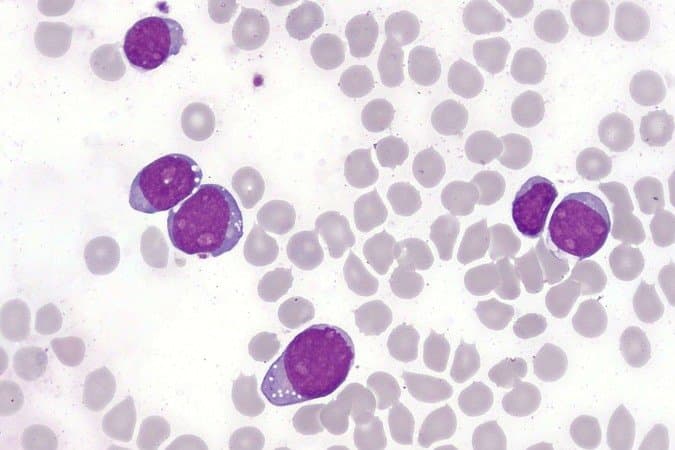
Células modificadas vencem leucemia agressiva e colocam pacientes em remissão histórica

GAZA: Escassez de suprimentos deixa palestinos desesperados por comida

O Escritório das Nações Unidas para a Coordenação de Assuntos Humanitários (Ocha) informou nesta quarta-feira (8) que as padarias no norte da Faixa de Gaza foram forçadas a fechar devido à escassez de suprimentos vitais.
“Não havia padarias ativas no norte, devido à falta de combustível, água e farinha de trigo, bem como aos danos sofridos por muitas”, disse a agência das Nações Unidas, em uma atualização diária.
Toda estrutura de Gaza está afetada com conflito entre Israel e Hamas, não existe eletricidade desde 11 de outubro e não é permitida a entrada de combustível. Isso resultou no encerramento da única central eléctrica da faixa costeira, de acordo com as informações da agência.
O acesso ao pão continua escasso, com o único moinho em funcionamento no território incapaz de moer trigo devido à falta de eletricidade e combustível e, segundo o Ocha, algumas pessoas recorreram a medidas desesperadas.
“Durante o dia, muitas pessoas que procuravam desesperadamente por comida invadiram as últimas três padarias com estoques restantes de farinha de trigo e levaram cerca de 38 toneladas métricas”, disse a agência.
Desde 7 de outubro, 11 padarias foram atingidas e destruídas, de acordo com Ocha. Apenas uma padaria contratada pelo Programa Alimentar Mundial e outras oito padarias no sul de Gaza estão fornecendo pão intermitentemente aos abrigos.
Quando há pão disponível, as pessoas fazem filas durante longas horas, ficando expostas a potenciais ataques aéreos israelitas, disse o Ocha.
“Cerca de 9.000 toneladas de grãos de trigo estão armazenadas em moinhos em Gaza, mas uma parte significativa está inacessível devido à destruição e às preocupações de segurança, juntamente com a escassez de combustível e eletricidade, acrescentou.
*com informações CNN Brasil